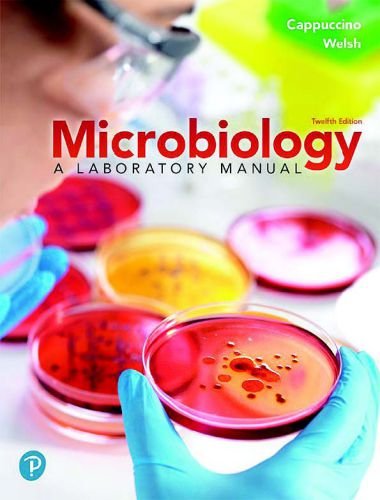
Microbiology a laboratory manual 12th edition

Microbiology: A Laboratory Manual 12th Edition
By James G. Cappuccino, Chad T. Welsh, Published: March 2019, FileType: PDF
Microbiology: A Laboratory Manual, 12th Edition provides students with a solid underpinning of microbiology laboratory work while putting increased focus on clinical applications and critical-thinking skills, as required by today’s instructors. The text is clear, comprehensive, and versatile, easily adapted to virtually any microbiology lab course and easily paired with any undergraduate microbiology text.
The 12th Edition has been extensively updated to enhance the student experience and meet instructor requirements in a shifting learning environment. Updates and additions include clinical case studies, equipment and material checklists, new experiments, governing body guidelines, and more. Microbiology Fundamentals: A Clinical Approach 4th Edition
Microbiology is a dynamic science. It constantly evolves as more information is added to the continuum of knowledge, and as microbiological techniques are rapidly modified and refined. The twelfth edition of Microbiology: A Laboratory Manual continues to provide a blend of traditional methodologies with more contemporary procedures to meet the pedagogical needs of all students studying microbiology. As in previous editions, this laboratory manual pro-vides a wide variety of critically selected and tested experiments suitable for undergraduate students in allied health programs, as well as elementary and advanced general microbiology courses.
This laboratory manual helps students develop manipulative skills and techniques essential for understanding the biochemical structure and function of a single cell. Its main goal is to encourage students to apply these laboratory skills in the vocational field of applied microbiology and allied health or to study life at the molecular level.
Direct Link For Paid Membership: –
This Book is Available For Premium Members Only (Register Here)
Unlock 3000+ Veterinary eBooks or Go To Free Download
Â
Direct Link For Free Membership: –
| Book Name:Â | Microbiology: A Laboratory Manual 12th Edition | |
| File Size:Â | 44 MB | |
| File Format:Â | ||
| Download Link:Â | Click Here | |
| Password: | PDFLibrary.Net (if Required) | |

